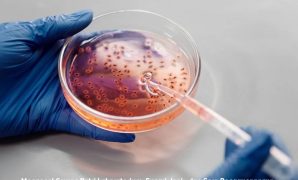

Buret laboratorium merupakan instrumen kaca berbentuk silinder panjang yang dilengkapi dengan garis ukur dan keran penghenti (stopcock) pada bagian bawahnya. Read more
Alat Laboratorium
Mengenal Fungsi Gelas Erlenmeyer sebagai Alat Laboratorium
Fungsi gelas erlenmeyer sangatlah penting. Meski begitu, apabila tidak tepat dalam menggunakannya, tentu fungsinya tak optimal. Bahkan pengguna tidak bisa Read more
Mengenal Penjepit Tabung Reaksi untuk Kegiatan Laboratorium
Penjepit tabung reaksi merupakan salah satu alat laboratorium yang tak asing lagi bagi siswa, mahasiswa maupun pekerja. Sebab, alat yang Read more
Mengenal Mikroskop Cahaya Binokuler Lebih Dalam
Mikroskop cahaya binokuler merupakan alat laboratorium yang berfungsi untuk meneliti benda-benda kecil yang tak kasat mata atau tidak terlihat. Mikroskop Read more
Mengenal Ragam Jenis Timbangan Analitik Laboratorium
Timbangan analitik laboratorium merupakan alat yang dirancang khusus untuk mengukur massa dengan tingkat presisi sangat tinggi. Keberadaan alat ini mampu Read more
Mengenal Seputar Alat Laboratorium Spektrofotometer
Alat laboratorium spektrofotometer mungkin sudah tidak asing bagi sebagian besar ahli Biologi, khususnya para tenaga di ruang laboratorium. Keberadaan spektrofotometer Read more
Ketahui Pengertian hingga Metode Penggunaan Hot Plate Stirrer
Pernah mendengar hot plate stirrer dan bertanya-tanya alat apakah itu? Plate stirrer sendiri merupakan salah satu alat yang digunakan untuk Read more
Mengenal Lebih Dekat Fungsi pH Meter Laboratorium
Saat pertama kali masuk ke dunia laboratorium, pasti banyak yang penasaran dengan berbagai alat yang dipakai. Salah satu alat yang Read more
Mengenal Cawan Petri Laboratorium, Fungsi, Jenis, dan Cara Penggunaannya
Dalam dunia penelitian ilmiah, akurasi dan ketelitian merupakan dua hal yang tidak bisa ditawar. Berbagai alat laboratorium pun hadir sebagai Read more
Corong Kaca Laboratorium, Alat Kecil dengan Peran Besar dalam Proses Percobaan
Di laboratorium, terdapat berbagai macam peralatan dengan bentuk serta fungsi yang beragam. Salah satunya adalah corong kaca laboratorium. Meski tampak Read more